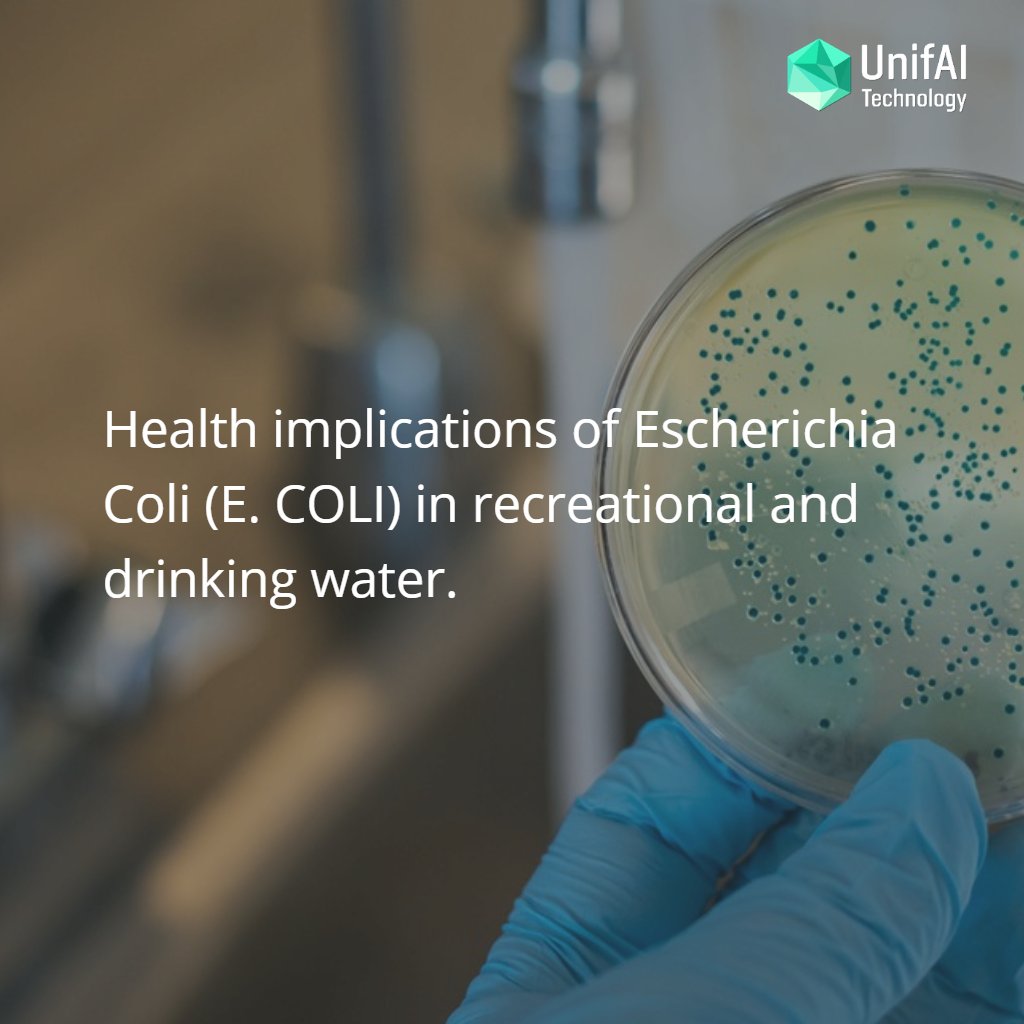
Nuno Silva tweet media

UnifAI Technology retweetledi

'By using an array of datasets and including real-time water quality sensors and putting that into an AI platform, you can understand the relationships between different datasets' @wessexwater @UnifaiTech #water #innovation #data #utilities utilityweek.co.uk/creating-a-rea…
English